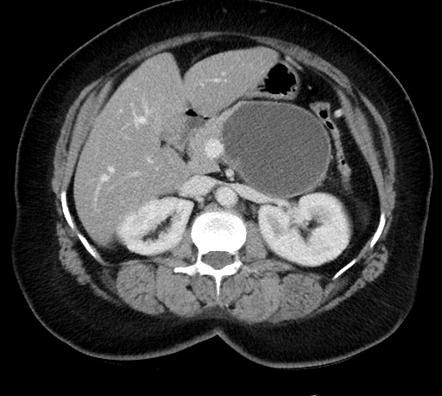
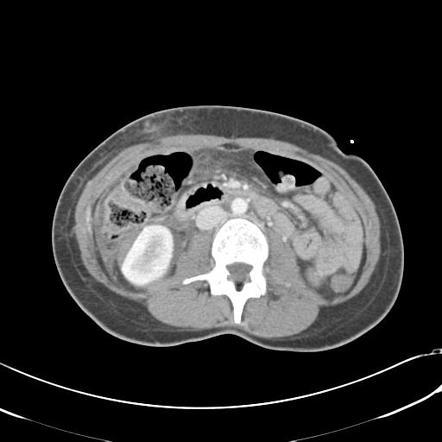
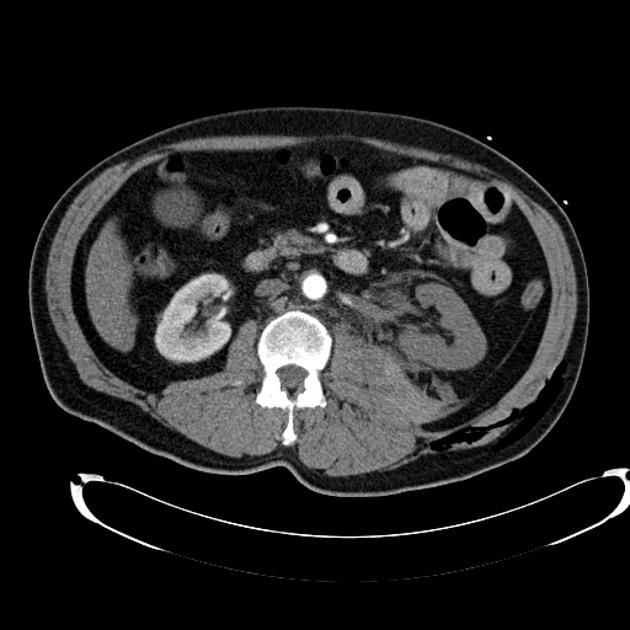
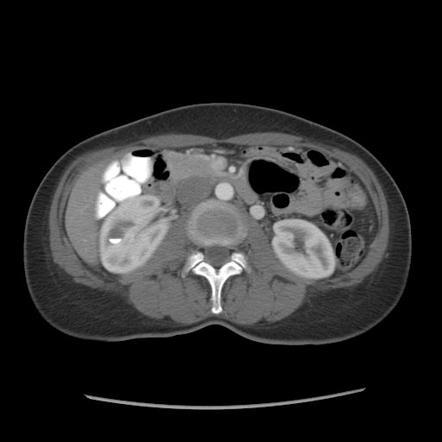

54F with abdominal pain, n/v

Closed loop obstruction
There is a cluster of fluid-distended loops of small bowel in the pelvis that are notable for relative absence of intraluminal gas, minimal enhancement of their mucosa, infiltrated mesentery, engorged mesenteric vessels and interloop ascites. The distal small bowel is of normal caliber.
—> findings suggestive of ischemia/closed loop include minimal enhancement of the mucosa and engorged mesenteric fat/vessels, and focal ascites.
—> in pt w/appropriate hx could also be a post-op intramesenteric hernia
54m w/cirrhosis 2/2 alcohol

Arterial phase CECT w/multiple hyperdense/hypervascular foci c/w tumor (these wash out on PV phase where the tumor thrombus is also more apparent) we also see cirrhosis w/small nodular border
Criteria to distinguish portal vein tumor thrombus (vs. bland thrombus) are contiguity with parenchymal tumor, expansion of the lumen of the vein, and enhancing thrombus.

Incidentally seen liver lesion.
Isodense to liver on other phases

FNH
homogeneously hypervascular on arterial phase imaging and nearly isodense to liver on other phases; the additional presence of a central scar is essentially pathognomonic.
—> in a younger woman w/o hx of cancer, can be dx from the CT appearance
—>hemangioma would be hypervascular but isodense to vessels, not liver.
Middle aged man c/o intermittent crampy abdominal pain and constipation

Diverticulosis w/concentric/circular muscular hypertrophy
—Also known as myochosis
get ‘cogwheel’ narrowing of the colonic lumen

RUQ pain, n/v

Gallstone eroded into duodenum, w/pneuobilia
”Bouveret syndrome”
—> gallstone iléus is by same mechanism but have SBO
—> mirizzi’s is where a stone intermittently compresses the CBD
64M w/hx of cirrhosis. P/w acute RUQ pain and this lesion had a pseudoaneurysm

HCC
Hypervascular liver mass in pt w/cirrhosis that spontaneously bleeds is essentially diagnostic of HCC
—> mets dont usually go to cirrhotic livers
—>
24 year old female with pelvic pain

Turbo-ovarian abscess
complex fluid next to the ovary w/appropriate history
IgG4 disease manifestations
MC is autoimmune pancreatitis
Can also get hepatobiliary involvement
in the chest, can see soft tissue infiltration/abnormal nodes and aortitis
—> can sometimes have normal IgG4 levels
Grandmother tumor

Serous Cystadenoma
many small cysts (>6 cysts
that are <2 cm) that may have a solid
appearance on CT due to apposition of
many cyst walls. MRI is useful to show
the cystic nature of the lesion.
hypervascular(unlike other cystic pancratic neoplasms), doesn’t cause ductal dilatation or tail atrophy (unlike adeno)
Central stellate calcs are classic
Mother Tumor
Mucinous Cystic Neoplasm
Middle aged women
benign but has malignant potential
consists of a single or a few
large cysts (<6 cysts that are >2 cm)
and typically occurs in the pancreatic
body and tail.
has a capsule (only other is SPEN)
can have peripheral calcs
Daughter Tumor

Solid and Papillary Epithelial Neoplasm (SPEN)
Young women and children, low malignant potential, typically resected.
large mass with heterogeneous solid and cystic areas.Hemorrhage is typical. Has a capsule, as does mucinous cystic neoplasm.

Crossing duct sign in Pancreas Divisum
failure of ventral and dorsal ducts to fuse
(duct of santorini is superior and drains to small (minor) papilla) while CBD always drains to major papilla
–> in divisum, main pancreatic duct drains into santorini and minor papilla, while wirsung only drains a small amount of pancreas and drains w CBD into major papilla
Pancreatic manifestations of VHL
inherited multisystemic disease w/increased risk of multiple malignancies and cysts in many organs
–>serous cystadenoma (grandma tumor) and neuroendocrine tumors
pancreatic manifestations of CF
either fatty atrophy of the pancreas
or replacement with innumerable cysts
fatty replacement of the pancreas –> exocrine insufficiency, neutropenia and bone dysplasias
Schwachman-Diamond Syndrome
2nd MCC pancreatic atrophy in childhood(first CF)

Corpus luteal cyst—>
unilocular cyst with thick, crenulated walls that enhance on CT (from peripheral vessels, correlates with ring of fire on US)
Type of functional ovarian cyst that forms when corpus luteum fails to involute after ovum is released
remnants of the follicle after ovulation; ranges from 2-5 cm in diameter but involutes as it matures. The corpus luteum produces estrogen and progesterone, maintaining optimum conditions for implantation if the ovum is fertilised:
fertilised: the corpus luteum continues to produce these hormones and maximizes the chance of implantation into the endometrium; it reaches a maximum size at ~10 weeks and finally resolves at around 16-20 weeks
not fertilised: the corpus luteum involutes and turns into a corpus albicans by around 2 weeks
In some instances (like twin pregnancies), may be more than one corpus luteum - (e.g. two corpora lutea)
what grade ?
Grade 1:
subcapsular hematoma or contusion, without laceration
what grade?

Grade II Renal trauma
superficial laceration ≤1 cm depth not involving the collecting system (no evidence of urine extravasation)
perirenal hematoma confined within the perirenal fascia

Grade III Renal Trauma
laceration >1 cm not involving the collecting system (no evidence of urine extravasation)
vascular injury or active bleeding confined within the perirenal fascia
What grade?

Grade IV renal trauma
laceration involving the collecting system with urinary extravasation
laceration of the renal pelvis and/or complete ureteropelvic disruption
vascular injury to segmental renal artery or vein
segmental infarctions without associated active bleeding (i.e. due to vessel thrombosis)
active bleeding extending beyond the perirenal fascia (i.e. into the retroperitoneum or peritoneum)
what grade?
Grade V
shattered kidney
avulsion of renal hilum or laceration of the main renal artery or vein: devascularisation of a kidney due to hilar injury
devascularised kidney with active bleeding
+ calcs/staghorn calculus

xanthogranulomatous pyelonephritis
what criteria are used to diffx benign from malignant ovarian lesions?
–> large solid components
–> wall thickness >3mm
–> septal thickness >3mm and/or nodularity
–>necrosis
layering calcified stones w/in the renal parenchyma
renal diverticulum.
will see it fill on CT also





















